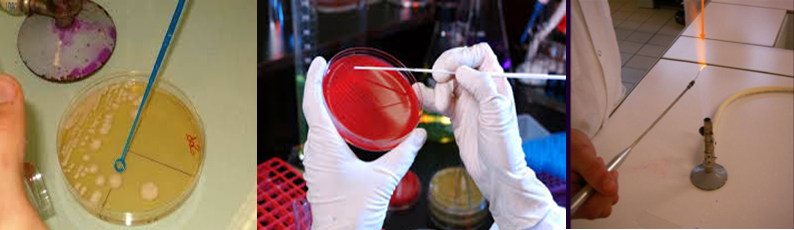

Plate-forme « Cours en ligne » de l'université Blida1
Résultats de la recherche: 1381

Analysis of experimental data (pharmacodynamics, pharmacokinetics).
Simulation of molecular mechanisms or drug interactions.
Processing of data from environmental or clinical toxicology.
Writing scientific reports with tools like LaTeX or Markdown.
This course is therefore a strategic lever for training researchers capable of using powerful, accessible and collaborative tools in a field where scientific rigour and transparency are crucial.
- Enseignant: Dr Eddaikra Atika
Dans le cadre de la
préparation des vols, le respect de la réglementation d’utilisation des avions
de transport public est nécessaire pour la sécurité aérienne. Ce cours abordera
le calcul de la limitation d’utilisation en croisière ainsi qu’à l’atterrissage.
Le respect de ses limitations permis de déterminer la masse maximale à ne pas dépasser
au décollage et à l’atterrissage. Le calcul sera effectué conformément à la règlementation
Européenne CS 25 et EU OPS

Le concept d’Opération unitaire suppose que tous les procédés de fabrication peuvent être décomposés en une suite d’opérations élémentaires comme absorption, extraction et distillation
Dans beaucoup d’opération unitaire, un composant (soluté) dans une phase est transféré dans une
transfert de chaleur.
Ce cours permet de vous familiariser avec les opérations unitaires en tous genres, connaitre les principales opérations, écrire les bilans de matière de ces processus et comprendre les schémas des procédés.
- Enseignant: Dadou salima
Le cours Opérations Unitaires (O_U) est destiné aux étudiants de 2eme années (L2) de l'institut des sciences et techniques appliquées, universite de Blida 1.

Le cours OU II est adressé aux étudiants inscrits en première année master de la filière de Génie des Procédés, option : Génie des Procédés des Matériaux.
Semestre: 2
Unité d’enseignement: UEF 1.2.1
Matière 1: Opérations unitaires II
VHS: 45h00 (Cours: 1h30 ; TD : 1h30)
Crédits: 4
Coefficient: 2
- Enseignant: CHABANE Leila
- Enseignant: chentir amina
Bienvenue au cours "Optimisation Combinatoire". Ce module est enseigné sur 8 semaines. Les objectifs généraux ou les visées d'apprentissages sont:
• Comprendre les bases de la programmation linéaire en nombres réels.
• Comprendre les bases de la programmation linéaire en nombres entiers.
• Apprendre les techniques de résolution des problèmes combinatoires.
• Analyser les problèmes combinatoires.
• Manipuler des solutions logicielles « solveurs ».
Prérequis
• Quelques connaissances en mathématiques : - Représentation graphique des droites ; - Matrices et calcul matriciel ;
• Quelques connaissances en algorithmiques : - Complexité linéaire, quadratique ; - Classes de complexité.
Afin que l’étudiant puisse assimiler les concepts de base sur l'Optimisation Combinatoire, le cours englobe plusieurs méthodes d’apprentissage ayant leurs spécificités et leurs avantages:
- Une série d’exercices est entamée après chaque unité d’apprentissage ou leçon. L’étudiant sera capable d’appliquer les savoirs en résolvant des exercices et des problèmes proposés.
- Des quiz sont publiés afin de tester les connaissances acquises. Après soumission du test, les réponses correctes seront affichées permettent à l’étudiant d’établir une synthèse sur ce qu’il a appris et de détecter les lacunes. L'étudiant pourra passer le quiz plusieurs fois.
Exercice 1 : Optimisation d’un programme linéaire par la méthode grahique
Rappel :
Un programme linéaire (PL) → forme canonique :
- 1er cas : si PL ne dépend que de deux variables principales → résolution graphique est possible.
- 2ème cas : si PL dépend de plus deux variables principales → résolution graphique est impossible.
Dans ce 2ème cas, il faut trouvez une méthode algébrique, c’est la méthode du simplexe (George Dantzig).
1er Méthode : résolution graphique :
A--Maximisation de la fonction objective (la fonction économique, des gains):
Exercice 1 :
Le but de cet exercice est de maximiser (on doit chercher) la fonction objective suivante :
M(X ;Y) = max(X ;Y) = Max (4*X + 5*Y)
En tenant compte des contraintes suivantes :
X ≥ 0 et Y ≥ 0
2*X + Y ≤ 8
X + 2*Y ≤ 7
Résolution graphique :
1- Transformer les inéquations en équations :
On doit transformer les inéquations en équations.
2*X + Y ≤ 8 → Y = -2*X + 8 équation D1
X + 2*Y ≤ 7 → Y = -X + 7 équation D2
On obtient ainsi deux droites.
2- Détermination des points d’intersections des deux droites D1 et D2:
2*X + Y = 8 équation D1
X + 2*Y = 7 équation D2
On peut aussi écrire en multipliant la 2ème équation par 2 et on aura :
2*X + Y = 8 équation D1
2*X + 4*Y = 14 équation D2
D2-D1 → 2*X - 2*X + 4*Y - Y= 14 -8
3*Y= 6
Y= 6/3 = 2
Je remplace Y par sa valeur dans l’équation D1 :
2*X + 2 = 8 donc 2*X = 8 – 2
2*X = 6 et X = 3
Donc A(3,2) est le point d’intersection entre D2 et D1
3. Détermination des points d’intersections des deux droites D1 et D2 avec l’axe des abscisses et l’axe des ordonnée :
3.1. Pour la droite D1 :
2*X + Y = 8
Si X= 0 donc Y = 8 donc on a le point B(0,8)
Si Y= 0 donc X = 4 donc on a le point C(4,0)
3.2. Pour la droite D2 :
X + 2*Y = 7
Si X= 0 donc Y = 7/2 = 3,5 donc on a le point D(0,3.5)
Si Y= 0 donc X = 7 donc on a le point E(7,0)
4. Représentation graphique :
Pour faire la représentation graphique, on doit construire le tableau suivant :
|
|
|
D1 |
D2 |
|
Points |
X |
Y |
Y |
|
A |
3 |
2 |
2 |
|
B |
0 |
8 |
- |
|
C |
4 |
0 |
- |
|
D |
0 |
- |
3,5 |
|
E |
7 |
- |
0 |
En utilisant le logiciel, on va tracer Y en fonction de X et on obtient le graphe suivant :

5. Représentation des sommets de domaine faisable :
Nous avons représenté sur le 1er graphe les différents points d’intersection. Dans le 2ème graphe nous allons présenter les sommets de domaine faisable.

D’après cet graphe, le domaine faisable est une surface comprise entre les sommets suivants : O, D, A et C avec O(0,0)
6. Recherche du point qui peut maximiser la fonction objective (la fonction économique):
Le but de cet exercice est de maximiser (on doit chercher) la fonction objective suivante :
M(X ;Y) = max(X ;Y) = Max (4*X + 5*Y)
Question :
Pour chacun des sommets (O, D, A et C), lequel des points peut maximiser la fonction objective (la fonction économique) ?
6.1. Pour le point D(0,3.5) :
Max (4*X + 5*Y) = 4*0 + 5*3,5 = 17,5
6.2. Pour le point A(3,2) :
Max (4*X + 5*Y) = 4*3 + 5*2 = 22
6.3. Pour le point C(4,0) :
Max (4*X + 5*Y) = 4*4 + 5*0 = 16
6.4. Pour le point O(0,0) :
Max (4*X + 5*Y) = 4*0 + 5*0 = 0
7. Conclusion :
Le point qui maximise notre fonction objective (programme linéaire) est le sommet solution A(3,2).
Si une entreprise cherche à maximiser son profil, elle doit produire :
X = 3 et Y = 2 pour avoir un chiffre d’affaire de 22.
************************************************************
Exercice 2 :
Le but de cet exercice est de maximiser (on doit chercher) la fonction objective suivante :
M(X ;Y) = max(X ;Y) = Max (4*X + 5*Y)
En tenant compte des contraintes suivantes :
X ≥ 0 et Y ≥ 0
2*X + Y ≤ 8
X + 2*Y ≤ 7
Y ≤ 3 (nouvelle contrainte par rapport à l’exercice 1)
On suit les mêmes étapes que l’exercice 1
Résolution graphique :
1- Transformer les inéquations en équations :
On doit transformer les inéquations en équations.
2*X + Y ≤ 8 → Y = -2*X + 8 équation D1
X + 2*Y ≤ 7 → Y = -X + 7 équation D2
Y ≤ 3 → Y = 3 équation D3
On obtient ainsi 3 droites.
2- Détermination des points d’intersections des deux droites D1 et D2:
2*X + Y = 8 équation D1
X + 2*Y = 7 équation D2
On peut aussi écrire en multipliant la 2ème équation par 2 et on aura :
2*X + Y = 8 équation D1
2*X + 4*Y = 14 équation D2
D2-D1 → 2*X - 2*X + 4*Y - Y= 14 -8
3*Y= 6
Y= 6/3 = 2
Je remplace Y par sa valeur dans l’équation D1 :
2*X + 2 = 8 donc 2*X = 8 – 2
2*X = 6 et X = 3
Donc A(3,2) est le point d’intersection entre D2 et D1
3.Détermination des points d’intersections des deux droites D1 et D3:
2*X + Y = 8 équation D1
Y = 3 équation D3
D1-D3 → 2*X + Y - Y= 8 - 3
2*X = 5
X = 5/2= 2,5
Donc B(2.5,3) est le point d’intersection entre D1 et D3
4.Détermination des points d’intersections des deux droites D2 et D3:
X + 2*Y = 7 équation D2
Y = 3 équation D3
Je remplace Y par sa valeur dans l’équation D2.
X + 2*3 = 7 donc X = 7-6 et X = 1
Donc C(1, 3) est le point d’intersection entre D2 et D3
5. Détermination des points d’intersections des droites D1, D2 et D3 avec l’axe des abscisses et l’axe des ordonnée :
5.1. Pour la droite D1 :
2*X + Y = 8
Si X= 0 donc Y = 8 donc on a le point D(0,8)
Si Y= 0 donc X = 4 donc on a le point E(4,0)
5.2. Pour la droite D2 :
X + 2*Y = 7
Si X= 0 donc Y = 7/2 = 3,5 donc on a le point F(0,3.5)
Si Y= 0 donc X = 7 donc on a le point G(7,0)
5.3. Pour la droite D3 :
Y = 3 quel que soit la valeur de X. En particulier le point H(0,3).
6. Représentation graphique :
Pour faire la représentation graphique, on doit construire le tableau suivant :
|
|
|
D1 |
D2 |
D3 |
|
Points |
X |
Y |
Y |
Y |
|
A |
3 |
2 |
2 |
3 |
|
B |
2,5 |
3 |
- |
3 |
|
C |
1 |
- |
3 |
3 |
|
D |
0 |
8 |
- |
3 |
|
E |
4 |
0 |
- |
3 |
|
F |
0 |
- |
3,5 |
3 |
|
G |
7 |
- |
0 |
3 |
|
H |
0 |
|
|
3 |
En utilisant le logiciel, on va tracer Y en fonction de X et on obtient le graphe suivant :

5. Représentation des sommets de domaine faisable :
Nous avons représenté sur le 1er graphe les différents points d’intersection. Dans le 2ème graphe nous allons présenter les sommets de domaine faisable.

D’après cet graphe, le domaine faisable est une surface comprise entre les sommets suivants : O, H, C, A et E avec O(0,0)
6. Recherche du point qui peut maximiser la fonction objective (la fonction économique):
Le but de cet exercice est de maximiser (on doit chercher) la fonction objective suivante :
M(X ;Y) = max(X ;Y) = Max (4*X + 5*Y)
Question :
Pour chacun des sommets (O, H, C, A et E), lequel des points peut maximiser la fonction objective (la fonction économique) ?
6.1. Pour le point H(0,3) :
Max (4*X + 5*Y) = 4*0 + 5*3= 15
6.2. Pour le point A(3,2) :
Max (4*X + 5*Y) = 4*3 + 5*2 = 22
6.3. Pour le point C(1,3) :
Max (4*X + 5*Y) = 4*1 + 5*3 = 19
6.4. Pour le point O(0,0) :
Max (4*X + 5*Y) = 4*0 + 5*0 = 0
6.5. Pour le point E(4,0) :
Max (4*X + 5*Y) = 4*4 + 5*0 = 16
7. Conclusion :
Le point qui maximise notre fonction objective (programme linéaire) est le sommet solution A(3,2).
Si une entreprise cherche à maximiser son profil, elle doit produire :
X = 3 et Y = 2 pour avoir un chiffre d’affaire de 22.
***************************************************************
Exercice 3 :
Une station de traitement des eaux usées (STEU) produit une eau de qualité qui peut être réutilisée dans l’industrie de textile (A : eau traitée produite) et une boue de qui peut être utilisée en agriculture (B : boue produite).
Une seule chaine de traitement est nécessaire pour l’élaboration de ces deux produits. La production de A nécessité :
1h30 de traitement (tA1) et 3h de main d’œuvre (tA2).
La production de B nécessité :
3h de traitement (tB1) et 1h de main d’œuvre (tB2).
L’ensemble des coûts de production et de prix de vente sont résumés dans le tableau suivant :
|
|
Produit A (X) |
Produit B (Y) |
|
Coût traitement Coût main d’œuvre Coût matière première Prix de vente unitaire |
At = 1,2 DA/h Amo = 4,6 DA/h MPA = 0,9 DA/produit VA = 41,5 DA |
Bt = 1,2 DA/h Bmo = 4,6 DA/h MPB = 1,0 DA/produit VB = 29,2 DA |
L’ensemble des contraintes de production sont :
- Durant un mois, on ne dispose que de 2025 h et de 1950 h qui sont réservés respectivement au traitement et à la main d’œuvre,
- Le coût mensuel pour la matière 1er ne pas dépasser 795 Da,
- De plus le marché mensuel ne peut pas absorber plus de 600 produits B.
Question :
Le but de cet exercice est de déterminer le programme mensuel de fabrication de ces deux produits afin de maximiser la marge totale sur les coûts variables.
Solution de l’exercice :
1er Méthode : résolution graphique :
1- Définition :
1-1. Définition des variables principles (VP) :
X : quantité de produits A à produire et à vendre par mois,
Y : quantité de produits B à produire et à vendre par mois
1-2. Définition de la fonction économique :
Marge sur les coûts variables mensuels à maximiser :
M(X ;Y) = max(X ;Y) = mA * X + mB * Y
Avec : mA = VA – [(tA1* At) + (tA2* Amo) + MPA]
mA = 41,5DA – [(1,5 h* 1,2 DA/h) + (3 h* 4,6 DA/h) + 0,9DA] = 25 DA
et
mB = VB – [(tB1* Bt) + (tB2* Bmo) + MPB]
mB = 29,2DA – [(3 h* 1,2 DA/h) + (1h* 4,6 DA/h) + 1DA] = 20 DA
Donc on doit chercher : Max (25*X + 20*Y)
1-3. Les contraintes :
1-3-1. Contraintes main d’œuvre (h) :
3*X + Y ≤ 1950
1-3-2. Contraintes traitement (h) :
1,5*X + 3*Y ≤ 2025
1-3-3. Contraintes coût matière 1er (DA) :
0,9*X + 1*Y ≤ 795
1-3-4. Contraintes marché du produit B (unité) :
Y ≤ 600
Toutes les données sont traduites par des équations et inéquations. Ce qui nous permet d’écrire la forme canonique du programme linéaire.
X ≥ 0 et Y ≥ 0
3*X + Y ≤ 1950
1,5*X + 3*Y ≤ 2025
0,9*X + 1*Y ≤ 795
Y ≤ 600
Max (25*X + 20*Y)
Résolution graphique :
2. Transformer les inéquations en équations :
On doit transformer les inéquations en équations.
3*X + Y ≤ 1950 → Y = -3*X + 1950 équation D1
1,5*X + 3*Y ≤ 2025 → Y = -0,5*X + 675 équation D2
0,9*X + 1*Y ≤ 795 → Y = -0,9*X + 795 équation D3
Y ≤ 600 → Y = 600 équation D4
On obtient ainsi quatre droites.
3- Détermination des points d’intersections des droites :
On déterminer les points d’intersections des droites deux à deux.
3.1. Détermination du point d’intersection des droites D1 et D2:
3*X + Y = 1950 équation D1
0,5*X + Y = 675 équation D2
D1-D2 → 3*X + 0,5*X = 1950-675
2,5*X= 1275
X= 1275/2,5
X = 510
Je remplace X par sa valeur dans l’équation D1 :
3*510 +Y = 1950 donc Y= 1950-3*510 = 1950-1530= 420
Donc A(510,420)
3.2. Détermination du point d’intersection des droites D1 et D3:
3*X + Y = 1950 équation D1
0,9*X + Y = 795 équation D3
D1-D3 → 3*X - 0,9*X = 1950-795
2,1*X = 1155
X = 1155/2,1=550
Je remplace X par sa valeur dans l’équation D1 :
3*550 +Y = 1950 donc Y= 1950-3*550= 300
Donc B(550,300)
3.3. Détermination du point d’intersection des droites D1 et D4:
3*X + Y = 1950 équation D1
Y = 600 équation D4
D1-D4 → 3*X = 1950-600 → X = 1350/3=450
Donc C(450,600)
3.4. Détermination du point d’intersection des droites D2 et D3:
0,5*X + Y = 675 équation D2
0,9*X + Y = 795 équation D3
D3-D2 → 0,9*X - 0,5*X =795–675
0,4*X =120
X=120/0,4=300
Je remplace X par sa valeur dans l’équation D2 :
0,5*300 +Y = 675 donc Y=675-0,5*300= 525
Donc D(300,525)
3.5. Détermination du point d’intersection des droites D2 et D4:
0,5*X + Y = 675 équation D2
Y = 600 équation D4
D2-D4 → 0,5*X = 675-600 → X =75/0,5=150
Donc E(150,600)
3.6. Détermination du point d’intersection des droites D3 et D4:
0,9*X + Y = 795 équation D3
Y = 600 équation D4
D3-D4 → 0,9*X = 795-600 → X =195/0,9=216,67
Donc F(216.67,600)
4. Détermination des points d’intersections des droites avec l’axe des abscisses et l’axe des ordonnée :
4.1. Pour la droite D1 :
Y = -3*X + 1950 équation D1
Si X= 0 donc Y = 1950 donc on a le point G(0,1950)
Si Y= 0 donc X = 1950/3 =650 donc on a le point H(650,0)
4.2. Pour la droite D2 :
Y = -0,5*X + 675 équation D2
Si X= 0 donc Y = 675 donc on a le point I(0,675)
Si Y= 0 donc X =675/0,5= 1350 donc on a le point J(1350,0)
4.3. Pour la droite D3 :
Y = -0,9*X + 795 équation D3
Si X= 0 donc Y = 795 donc on a le point K(0,795)
Si Y= 0 donc X =795/0,9= 883,34 donc on a le point L(883.34,0)
4.4. Pour la droite D4 :
Y = 600 quel que soit la valeur de X. En particulier le point M(0,600).
5. Représentation graphique :
Pour faire la représentation graphique, on doit construire le tableau suivant :
|
|
|
D1 |
D2 |
D3 |
D4 |
|
Points |
X |
Y |
Y |
Y |
Y |
|
A |
510 |
420 |
420 |
- |
600 |
|
B |
550 |
300 |
- |
300 |
600 |
|
C |
450 |
600 |
- |
- |
600 |
|
D |
300 |
- |
525 |
525 |
600 |
|
E |
150 |
- |
600 |
- |
600 |
|
F |
217 |
- |
- |
600 |
600 |
|
G |
0 |
1950 |
- |
- |
600 |
|
H |
650 |
0 |
- |
- |
600 |
|
I |
0 |
- |
675 |
- |
600 |
|
J |
1350 |
- |
0 |
- |
600 |
|
K |
0 |
- |
- |
795 |
600 |
|
L |
883,34 |
- |
- |
0 |
600 |
|
M |
0 |
- |
- |
- |
600 |
En utilisant le logiciel EXCEL, on va tracer Y en fonction de X et on obtient le graphe suivant :

6. Représentation des sommets de domaine faisable :
Nous avons représenté sur le 1er graphe les différents points d’intersection. Dans le 2ème graphe nous allons présenter les sommets de domaine faisable.

D’après cet graphe, le domaine faisable est une surface comprise entre les sommets suivants : O, M, E, D, B et H avec O(0,0).
7. Recherche du point qui peut maximiser la fonction objective (la fonction économique):
Le but de cet exercice est de maximiser (on doit chercher) la fonction objective suivante :
M(X ;Y) = max(X ;Y) = Max (25*X + 20*Y)
Question :
Pour chacun des sommets (O, M, E, D, B et H), lequel des points peut maximiser la fonction objective (la fonction économique) ?
6.1. Pour le point H(650,0) :
Max (25*X + 20*Y) = 25*650 + 20*0 = 16250
6.2. Pour le point B(550,300) :
Max (25*X + 20*Y) = 25*550 + 20*300 = 19750
6.3. Pour le point C(300,525) :
Max (25*X + 20*Y) = 25*300 + 20*525 = 18000
6.4. Pour le point O(0,0) :
Max (25*X + 20*Y) = 25*0 + 20*0 = 0
6.5. Pour le point E(150,600) :
Max (25*X + 20*Y) = 25*150 + 20*600 = 15750
6.6. Pour le point M(0,600) :
Max (25*X + 20*Y) = 25*0 + 20*600 = 12000
7. Conclusion :
Le point qui maximise notre fonction objective (programme linéaire) est le sommet solution B(550,300).
Si la STPU cherche à maximiser son profil, elle doit produire :
X = 550 (550 unités (m3) d’eau traitée), et Y = 300 (300 unités (tonnes) de boues) pour avoir un chiffre d’affaire de 19750 DA.
****************************************************************
Exercice 4 :
En utilisant la méthode graphique optimiser (maximiser) la fonction objective suivante :
M(X ;Y) = max(X ;Y) = Max (300*X + 200*Y)
En tenant compte des contraintes suivantes :
X ≥ 0 et Y ≥ 0
X + 2*Y ≤ 20
2*X + Y ≤ 22
**************************************************************
Exercice 5 :
En utilisant la méthode graphique optimiser (maximiser) la fonction objective suivante :
M(X ;Y) = max(X ;Y) = Max (130*X + 100*Y)
En tenant compte des contraintes suivantes :
X ≥ 0 et Y ≥ 0
1,5*X + Y ≤ 27
X + Y ≤ 21
0,3*X + 0,5*Y ≤ 9
**********************************************
Exercice 6 :
En utilisant la méthode graphique optimiser (maximiser) la fonction objective suivante :
M(X ;Y) = max(X ;Y) = Max (10*X + 20*Y)
En tenant compte des contraintes suivantes :
X ≥ 0 et Y ≥ 0
4*X + 2*Y ≤ 20
8*X + 8*Y ≤ 20
2*X ≤ 10
*****************************************************
****************************************************************
B--Minimisation de la fonction objective (la fonction économique, des coûts):
Exercice 1 :
Une entreprise vise à minimiser ses coûts en utilisant la fonction objective suivante :
Min(X ;Y) = Min (24*X + 20*Y)
En tenant compte des contraintes suivantes :
X ≥ 0 et Y ≥ 0
X + Y ≥ 30
X + 2*Y ≥ 40
Question :
Utiliser la méthode graphique pour minimiser la fonction objective.
Résolution graphique :
1- Transformer les inéquations en équations :
On doit transformer les inéquations en équations.
X + Y = 30 D1
X + 2*Y= 40 D2
On obtient ainsi 2 droites.
2- Détermination des points d’intersections des deux droites D1 et D2:
X + Y = 30 D1
X + 2*Y= 40 D2
D2-D1 → X - X + 2*Y - Y= 40 - 30
Y= 10
Je remplace Y par sa valeur dans l’équation D1 :
X + 10 = 30 donc X = 20
Donc A(20,10) est le point d’intersection entre D2 et D1
3. Détermination des points d’intersections des droites D1, D2 avec l’axe des abscisses et l’axe des ordonnée :
5.1. Pour la droite D1 :
X + Y = 30 D1
Si X= 0 donc Y = 30 donc on a le point B(0,30)
Si Y= 0 donc X = 30 donc on a le point C(30,0)
5.2. Pour la droite D2 :
X + 2*Y= 40 D2
Si X= 0 donc 2*Y = 40 et Y = 20 donc on a le point D(0,20)
Si Y= 0 donc X = 40 donc on a le point E(40,0)
6. Représentation graphique :
Pour faire la représentation graphique, on doit construire le tableau suivant :
|
|
|
D1 |
D2 |
|
Points |
X |
Y |
Y |
|
A |
20 |
10 |
10 |
|
B |
0 |
30 |
- |
|
C |
30 |
0 |
- |
|
D |
0 |
- |
20 |
|
E |
40 |
- |
0 |
En utilisant le logiciel, on va tracer Y en fonction de X et on obtient le graphe suivant :

5. Représentation des sommets de domaine faisable :
Nous avons représenté sur le 1er graphe les différents points d’intersection. Dans le 2ème graphe nous allons présenter les sommets de domaine faisable.


D’après cet graphe, la partie supérieure du graphe (délimitée par points B, A et E) est la partie dans laquelle on peut réaliser le minimum de coûts.
6. Recherche du point qui peut minimiser la fonction objective (la fonction économique):
Le but de cet exercice est de minimiser (on doit chercher) la fonction objective suivante :
Min(X ;Y) = Min (24*X + 20*Y)
Question :
Pour chacun des sommets (B, A et E), lequel des points peut minimiser la fonction objective (la fonction économique) ?
6.1. Pour le point B(0,30) :
Min (24*X + 20*Y)=24*0+20*30=600
6.2. Pour le point A(20,10) :
Min (24*X + 20*Y)=24*20+20*10= 680
6.3. Pour le point E(40,0) :
Min (24*X + 20*Y)=24*40+20*0= 960
7. Conclusion :
Le point qui minimise notre fonction objective (programme linéaire) est le sommet solution B(0,30).
Si une entreprise cherche à minimiser ces coûts, elle doit produire :
X = 0 et Y = 30. Avec Min (24*X + 20*Y)=24*0+20*30=600.
****************************************************************
Exercice 2 :
En utilisant la méthode graphique minimiser la fonction objective suivante :
Min(X ;Y) = Min (130*X + 100*Y)
En tenant compte des contraintes suivantes :
X ≥ 0 et Y ≥ 0
1,5*X + Y ≥ 27
X + Y ≥ 21
0,3*X + 0,5*Y ≥ 9
**********************************************
Exercice 3 :
En utilisant la méthode graphique minimiser la fonction objective suivante :
Min(X ;Y) = Min (10*X + 20*Y)
En tenant compte des contraintes suivantes :
X ≥ 0 et Y ≥ 0
4*X + 2*Y ≥ 20
8*X + 8*Y ≥ 20
2*X ≥ 10
**********************************************************

Ce cours s'adresse plus particulièrement à des étudiants de 1ier année Master Avionique . Objectif principal de transmettre à l'étudiant les notions de base qui lui permettent de comprendre et d’appliquer des techniques de transmissions des données optique appliquée dans le domaine avionique en Bus ARINC en transmission numérique .
- Enseignant: Aero Transversale S2
- Enseignant: KRIM MOHAMED
Le cours ''Organisation et Gestion des Entreprises'' est destiné aux étudiants de Master1/ option Matériaux de Génie Civil. Il a pour objectif de répondre aux questions essentielles, posées par les étudiants en cursus universitaire, qui permettent de mieux comprendre c'est quoi l’entreprise en génie civil, les secteurs composants ce domaine, le fonctionnement de l'entreprise, son organisation et son lien avec l'Administration (Maître de l'ouvrage) et le BET (Maître de l'oeuvre).
Ce cours est composé des chapitres suivants:
- Projet en Génie Civil/ Phasage
- Notion d’Entreprise dans le secteur BTPH
- Doctrines d’Organisation/ Planification
- L’ordonnancement (méthode PERT et graphe GANTT)
- Gestion d’une entreprise (Administrative- Economique- et Sociale)
- Applications et Exemples
Dr M.ABDESSEMED
- Enseignant: ABDESSEMED Mouloud
- Enseignant: FT S2 Découverte
cette matière consiste à donner aux étudiants de la spécialité les notion de bases sur la planification de la production afin de :
- Identifier les différentes caractéristiques du produit
- Gérer et optimiser la production de un ou plusieurs ateliers
- Garantir et maîtriser la production
- Etre capable de collecter les données de la production et d’analyser ces dernières suivant des méthodes afin de ressortir avec un plan d’amélioration
- Enseignant: mouffok nassim
- Chapitre 1: Introduction aux OGM
- Chapitre 2: transgenèse
- Chapitre 3: Transgenèse animale
- Chapitre 4: Application des biotechnologies végétales
- Chapitre 5: Techniques d’édition génomiques et OGM
Public ciblé: Le cours est destiné aux étudiants de Master 2 Génétique
Objectifs du cours:
• Comprendre le contexte et l'histoire des OGM.
• Explorer les techniques du génie génétique appliquées à la production d’OGMs.
• Evaluer les tendances actuelles dans la production d’aliments génétiquement modifiés et leurs implications.
• Comprendre les avancées et contrôles réglementaires pour les aliments génétiquement modifiés.
- Enseignant: benyahia nourreddine
Il permet de gérer des données bibliographiques et des documents de recherche (PDF et Images).

Le cours "Outils mathématiques" est un cours de mathématiques de base destiné aux étudiants de première année de la Faculté des sciences de l'Université de Blida 1/ ISTA. Le cours est divisé en quatre modules :
- Calcul algébrique : Ce module couvre les bases du calcul algébrique, notamment les transformations d'expressions, les règles de proportionnalité, les racines, les puissances et les logarithmes, et la conversion d'unités.
- Analyse réelle et applications : Ce module couvre les notions de fonction, de représentation graphique et d'interprétation, de modèle linéaire et de matrices, de calcul différentiel et d'applications, et de traitement de données.
- La fonction logarithme décimal : Ce module couvre les propriétés de base de la fonction logarithme décimal et l'échelle logarithmique.
L'objectif du cours est de renforcer les bases de mathématiques des étudiants afin qu'ils puissent les appliquer aux disciplines scientifiques.
Voici un résumé plus détaillé de chaque module :
Calcul algébrique
- Transformation d'expression : Les étudiants apprendront à transformer des expressions mathématiques en utilisant des règles et des techniques spécifiques.
- Règles de proportionnalité : Les étudiants apprendront à résoudre des problèmes impliquant des proportions et des taux.
- Racines, puissances et logarithmes : Les étudiants apprendront à travailler avec les racines, les puissances et les logarithmes.
- Conversion d'unités : Les étudiants apprendront à convertir des unités de mesure.
Analyse réelle et applications
- Notion de fonction : Les étudiants apprendront la définition d'une fonction et ses différents types.
- Représentations graphiques et interprétation : Les étudiants apprendront à représenter graphiquement des fonctions et à interpréter les résultats.
- Modèle linéaire et matrices : Les étudiants apprendront à résoudre des systèmes d'équations linéaires et à travailler avec des matrices.
- Calcul différentiel et applications : Les étudiants apprendront à calculer les dérivées des fonctions et à appliquer ces dérivées à des problèmes concrets.
- Traitement de données : Les étudiants apprendront à effectuer des analyses statistiques sur des données.
- La fonction logarithme décimal : Les étudiants apprendront les propriétés de base de la fonction logarithme décimal et l'échelle logarithmique.
Le cours est évalué par un examen écrit composé d'exercices.

Description du cours
Lors des premières étapes de controle de qualité des aliments, les risques liés à la manipulation des micro-organismes ne sont pas clairs dont l'identité et le pouvoir pathogène sont souvent inconnus donc il faut que le microbiologiste soit toujours conscient aux risques qui peuvent survenir et il doit parfaitement maitriser le travail dans des conditions aseptiques pour éviter tout risque de contamination croisée.
Il est impérativement important que le manipulateur doit connaitre parfaitement les germes recherchés et manipulés, leurs voies de pénétrations dans l'organisme et aussi les meilleures méthodes de manipulations pour minimiser les risques.
Le présent cours s’articule autour de 5 chapitres, le premier chapitre intitule :le travail aseptique, le deuxième chapitre, traite la description du microscope et les techniques des préparations microscopiques, le troisième détaille les techniques d'estimation des populations microbiennes, le quatrième chapitre englobe les techniques d'isolement et de sélection des germes et le dernier chapitre traite la croissance bactérienne.
Public cible
Ce cours est destiné aux étudiants de la 1er année Licence professionnelle Tronc commun de l’Institut des Sciences et Techniques Appliquées de l’Université de Blida 1.
Objectifs généraux
Faire acquir les principes des conditions aseptiques pour manipuler et se protéger des contaminations et connaitre les consignes de sécurité et les régles de travail dans un laboratoire de microbiologie et de maitriser les principaux techniques de la microbiologie générales.
- Enseignant: HAMOUDA ALI Imane
Public cible
Ce cours est destiné aux étudiants de la 1er année Licence professionnelle Tronc commun de l’Institut des Sciences et Techniques Appliquées de l’Université de Blida 1.
Objectifs
A l'issu de ce cours, l'apprenant sera capable de :
- Connaitre la méthodologie et les techniques d’identification des micro-organismes
- Mise en œuvre des techniques d’identification taxonomique des micro-organismes (bactéries, archéobactéries, champignons)
- Connaitre les techniques générales de culture et de conservation des micro-organismes
- Enseignant: HAMOUDA ALI Imane

Ce cours est programmé en S5 pour le cycle L3 ISIL. Il traite sur la modélisation des SI opérationnels (SIO) et des SI décisionnels (SID). En dehors de la modélisation, une synthèse sur tous les aspects liés aux SI est présentée :
- Rappel sur les SI
- SIO vs SID
- Architecture des SI
- SGBD
- Formats de données : fichiers plats, documents XML, BD relationnelles, données multimédias
- ERP : modèle unifié des données, modules fonctionnels intégrés et processus métier
- Notion d'hétérogénéité des données
- Intégration des données
- Données massives (Big Data)
- Modélisation Entité/Association
- Modélisation Objet
- Introduction aux Systèmes d'Information Décisionnels (SID)
- Entrepôts de données
- Modélisation dimensionnelle
- Enseignant: Bala Mahfoud
Le cours de Outils mathématiques est destine aux étudiants de 1ere années de l'institut des sciences et techniques appliquées de l'université de Blida 1.
- Enseignant: kebour omar

La recherche documentaire est la première étape à réaliser avant d’entreprendre une étude donnée. Elle vise essentiellement à identifier et localiser des ressources informationnelles permettant de faire l’état de l’art sur le sujet de travail. Les outils de recherche ont bien évolué, cela dit, il est important de les connaitre pour en faire un usage approprié.
Public cible
Ce cours est destiné aux étudiants de Master 2, option Gestion durable des déchets et procédés de traitement. Mais également à tous les étudiants inscrits en Master 2 toutes spécialités confondues, vu qu'ils sont en phase de préparation d'un mémoire de Master.
Objectifs généraux
A l'issus de ce cours, l'étudiant sera capable de :
- Connaître les étapes d'une recherche documentaire.
- Connaître les principaux outils de recherche documentaire.
- Connaître des méthodologies de lecture et d'exploitation de la littérature scientifique et technique.
- Concevoir des documents scientifiques et techniques.
- Dr.: Ft découverte
- Dr.: Lazli Wassila